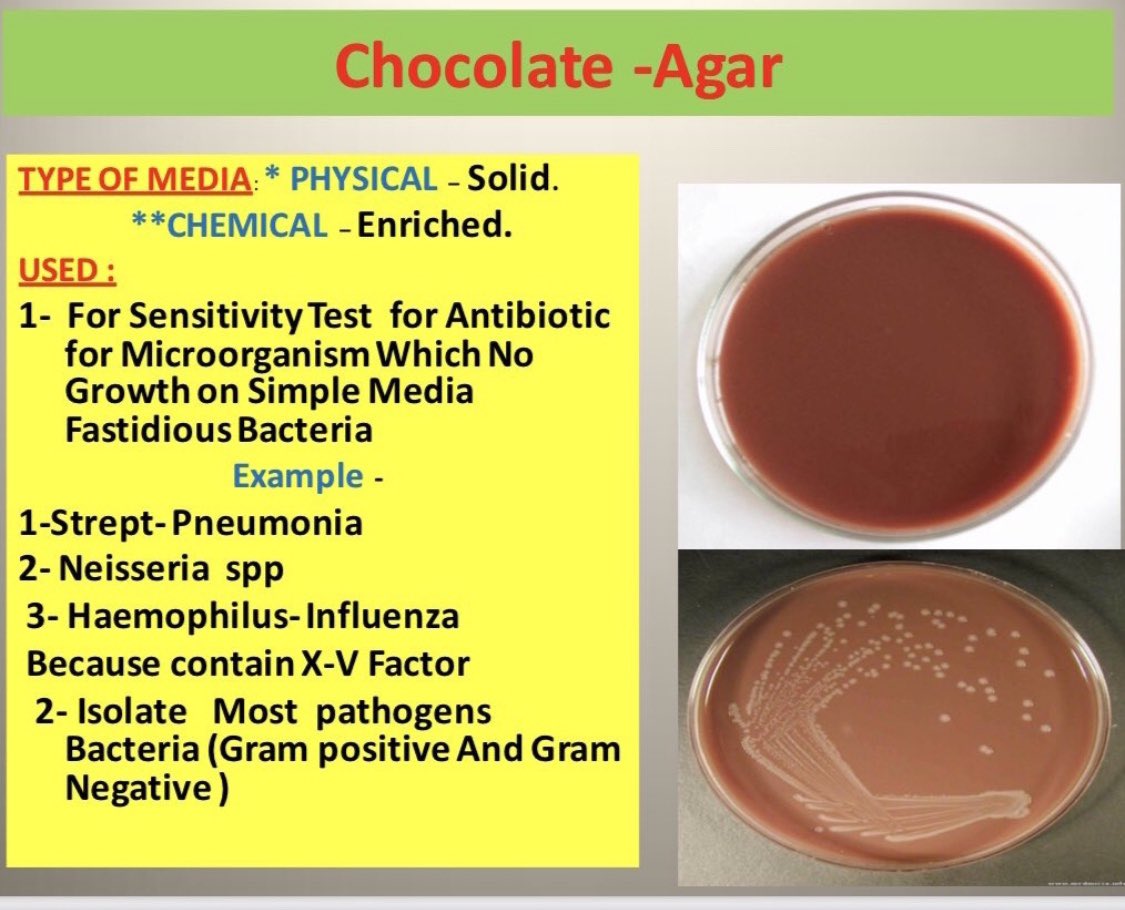
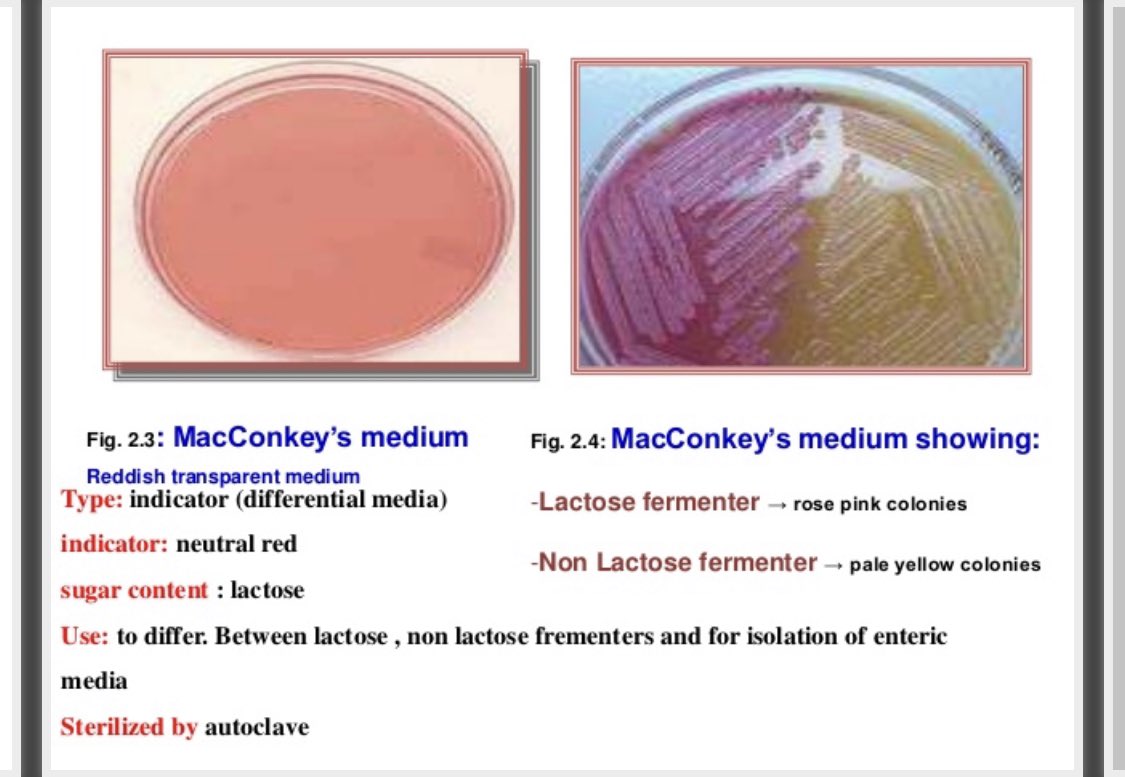
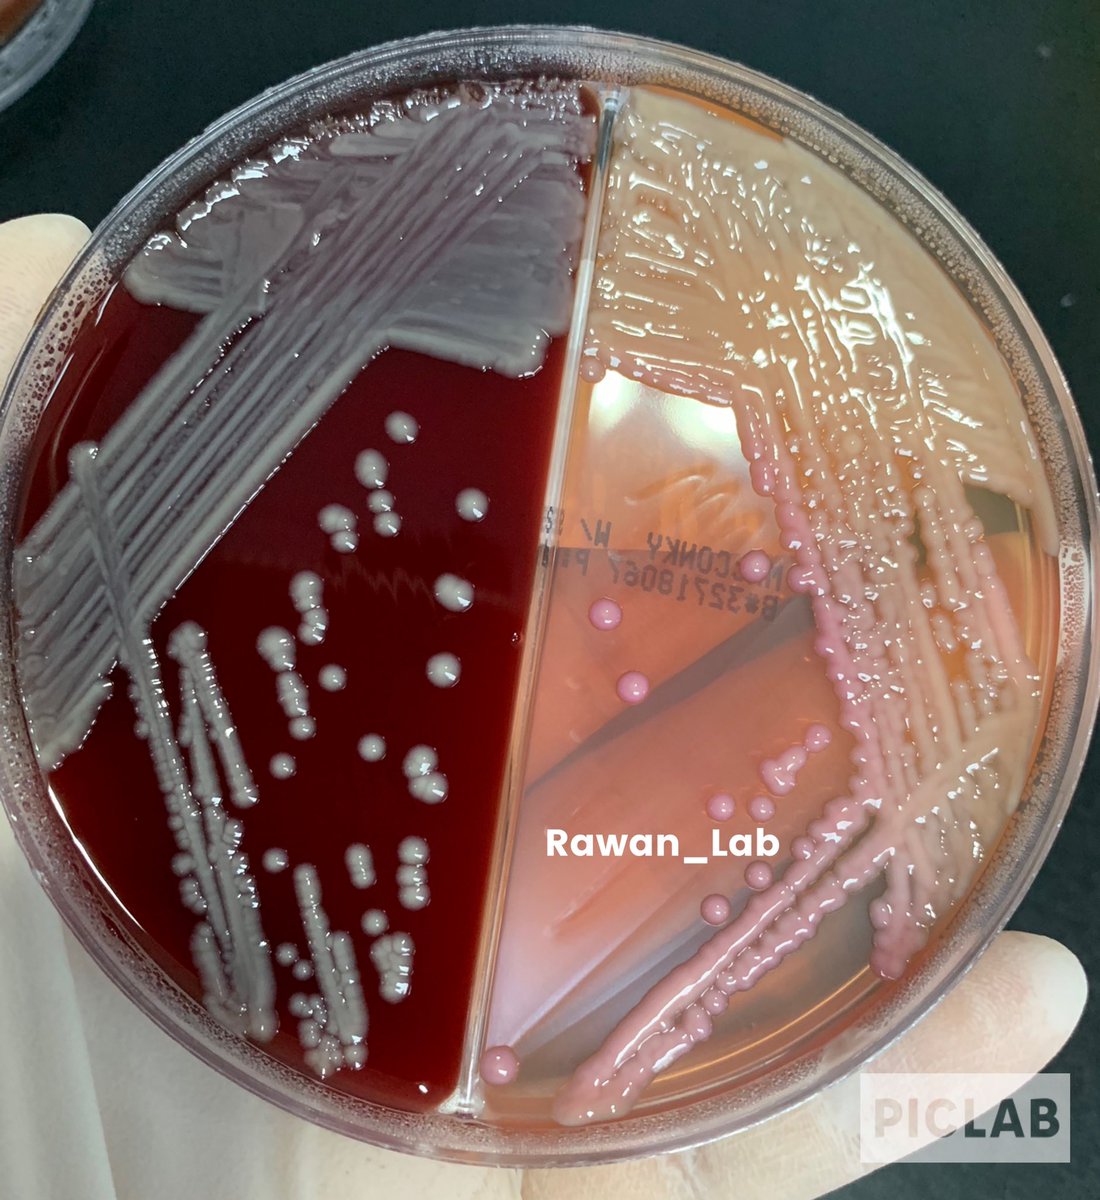
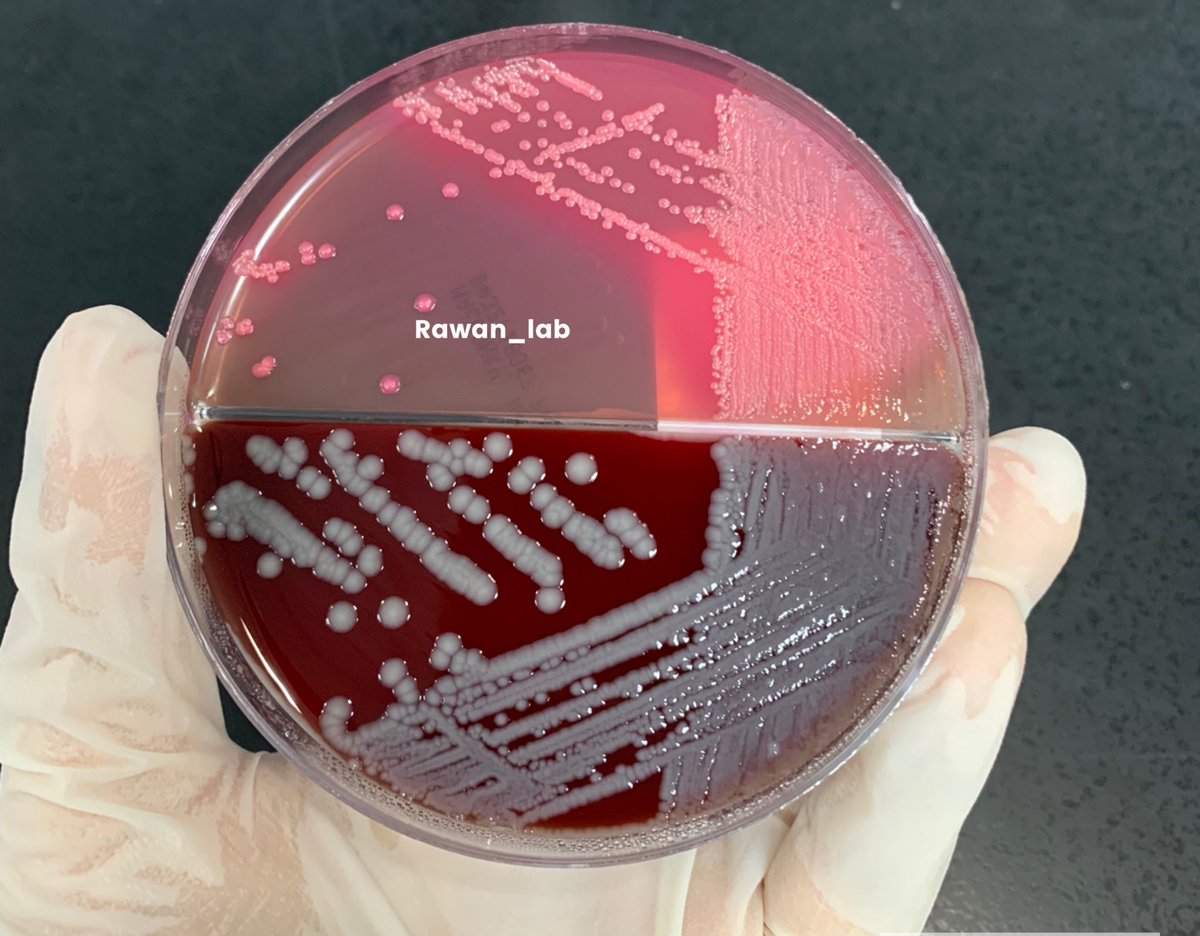
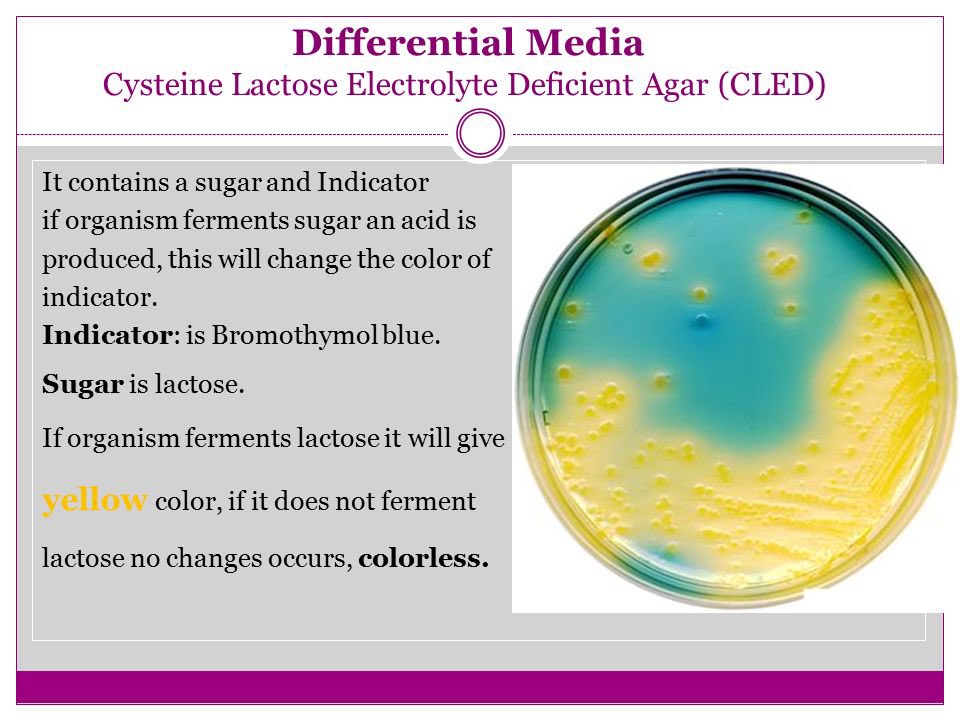
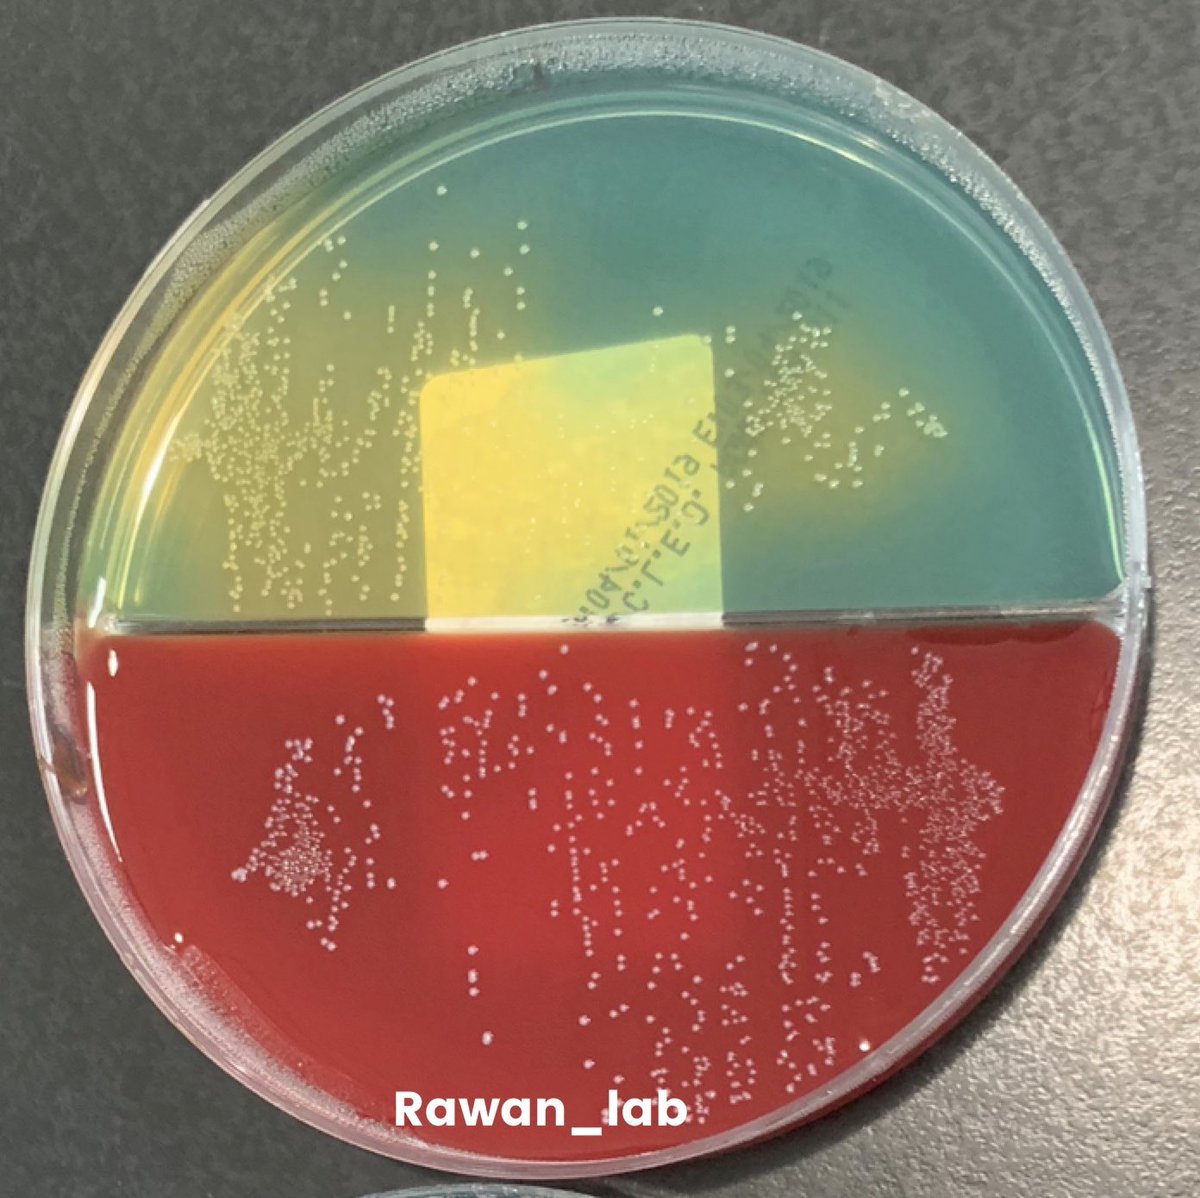
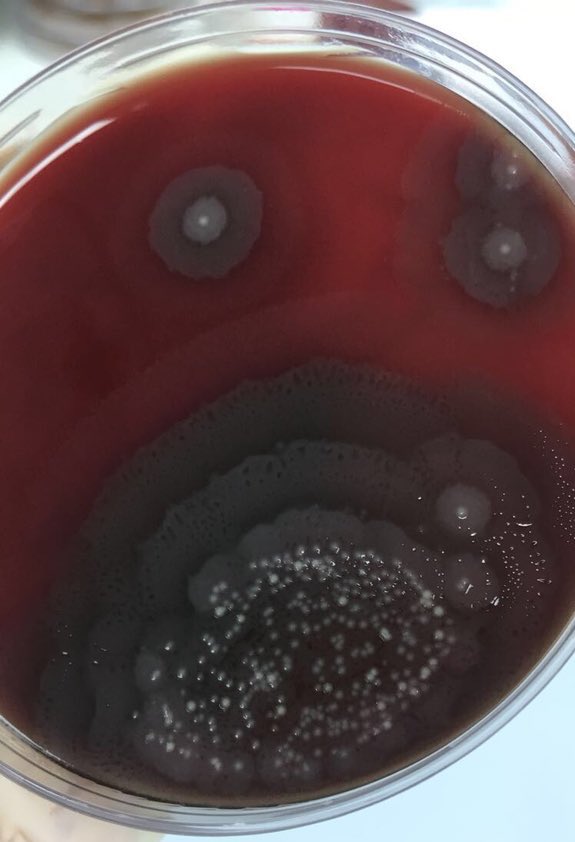
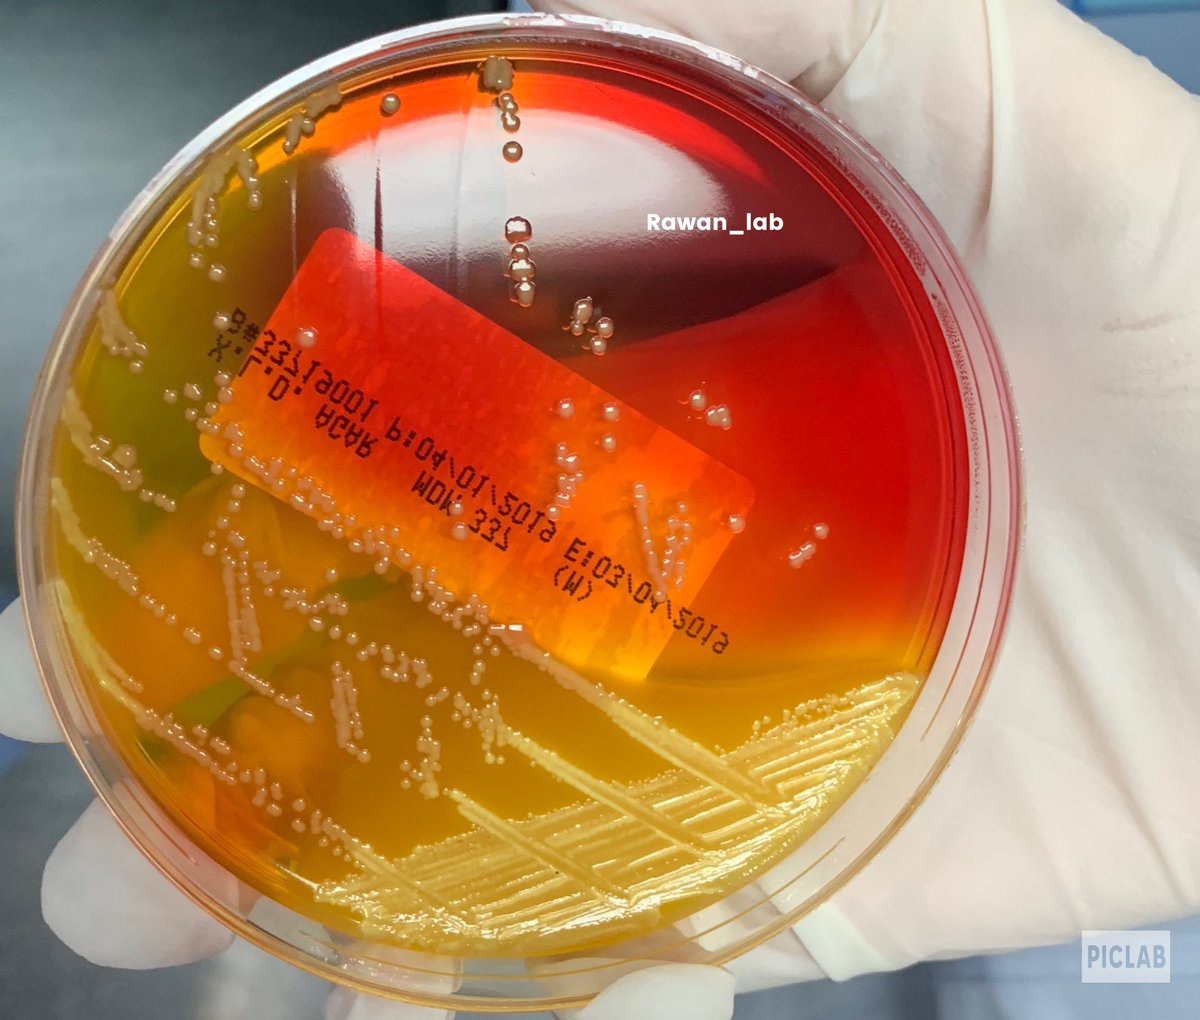
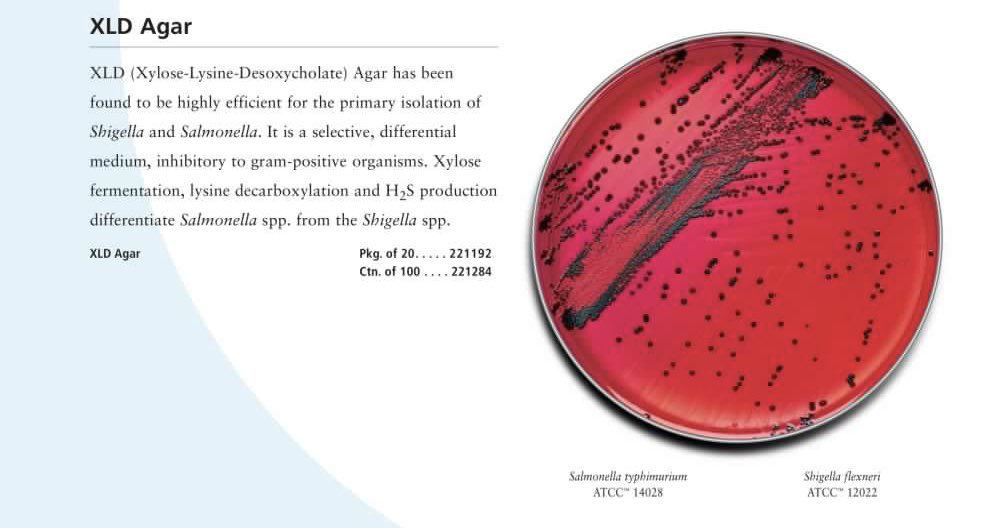
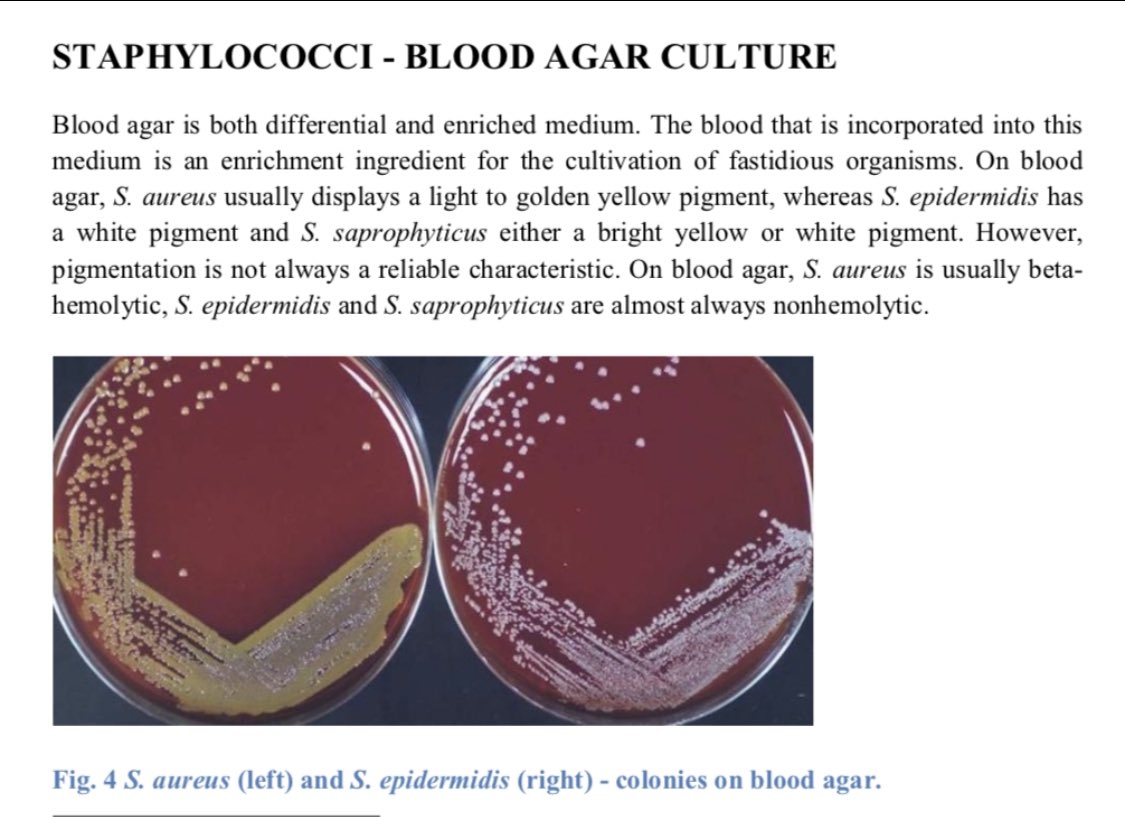
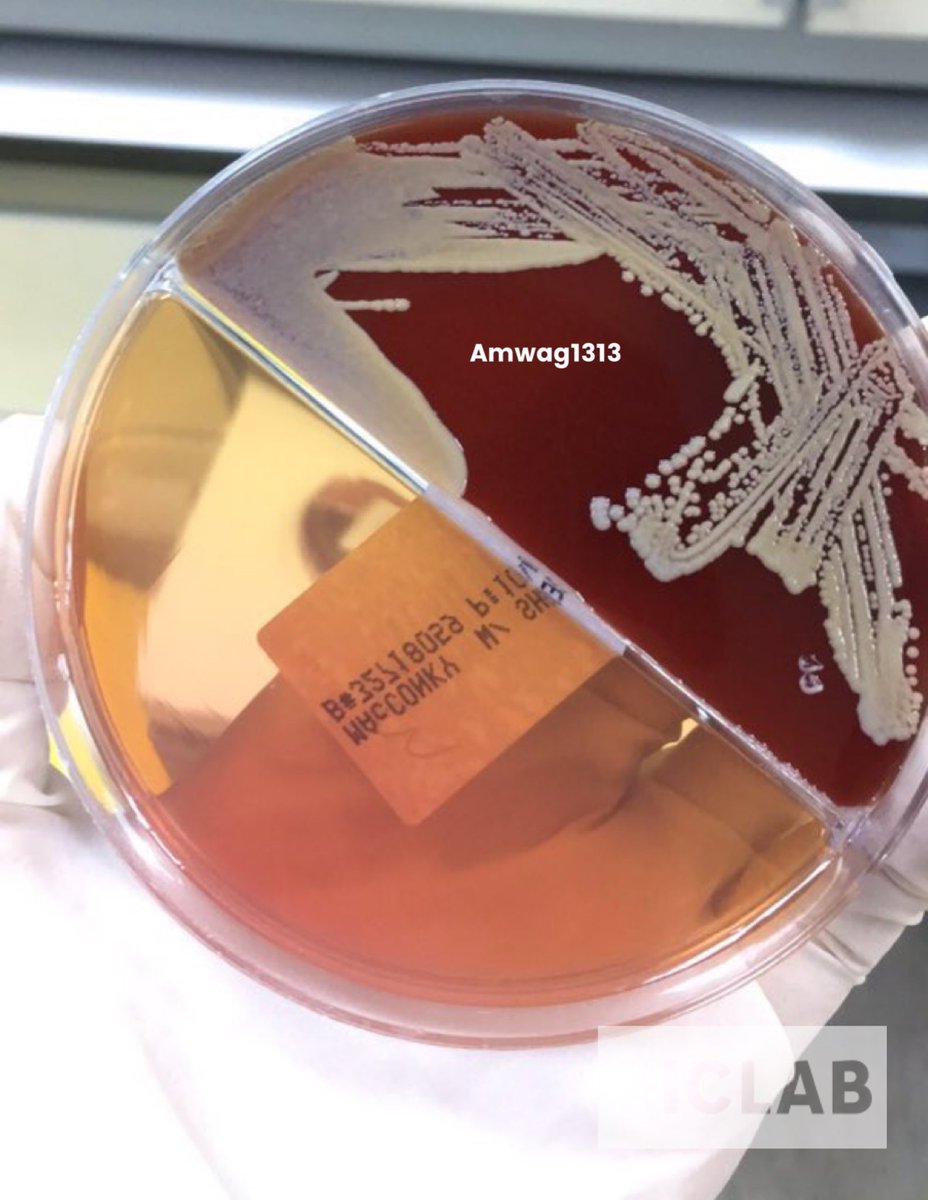
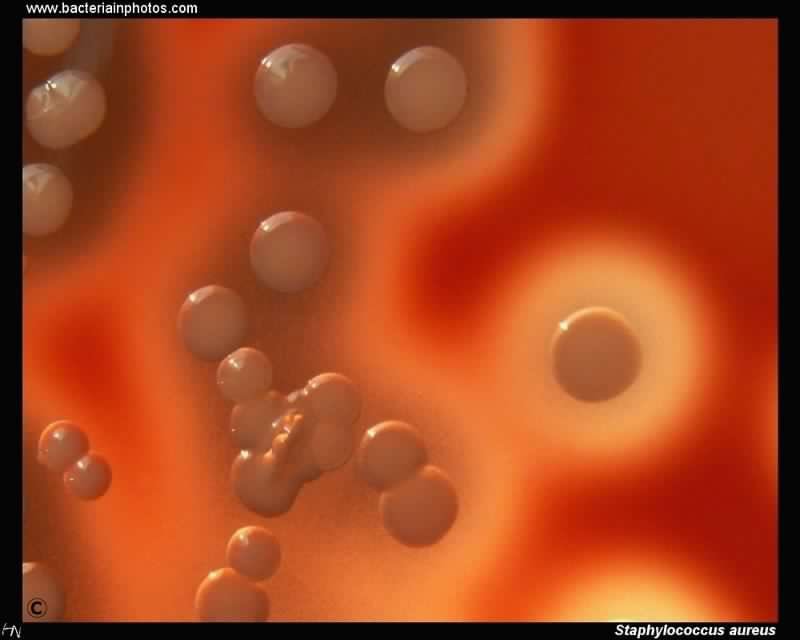

-ليه CLED؟ عشان نتعرف على البكتيريا الي معروف انها تسوي UTI وكمان بيمنع لنا الSwarming زي الي بتسويه الproteus، صورة الswarming من تصوير @ex_sarah😍✨
-خلاص اتأكدنا انها Staph بس أي نوع؟
هي ثلاثة أنواع الي تهمنا:
- S.aureus وتكون Coagulase + وتسوي أحيانًا hemolysis واضح ومميز على الblood agar ويكون لونها golden yellow 😍💛
-S.epidermidis + S. saprophyticus
وتكون Coagulase- واختصارها(CONS)
-الصورة الثانية من تصوير @Amwag1313✨
هي ثلاثة أنواع الي تهمنا:
- S.aureus وتكون Coagulase + وتسوي أحيانًا hemolysis واضح ومميز على الblood agar ويكون لونها golden yellow 😍💛
-S.epidermidis + S. saprophyticus
وتكون Coagulase- واختصارها(CONS)
-الصورة الثانية من تصوير @Amwag1313✨
طلعت لنا Strept كيف نفرق بين انواعها🤷🏻♀️
عن طريق نوع الhemolysis على الblood agar
هالصورة توضح لنا كل شيء⤵️✨
@SA_Microbiology
عن طريق نوع الhemolysis على الblood agar
هالصورة توضح لنا كل شيء⤵️✨
@SA_Microbiology
وهنا صورة لOptochin disk للتفريق بين:
-S.pneumoiae وS.viridans 💡
🔴كيف نربط ؟ viridans من اسمها viri قوية وتنمو م عليها ف ال Optochin😅
-الصورة الثانية من @Monzirelnino ✨
-S.pneumoiae وS.viridans 💡
🔴كيف نربط ؟ viridans من اسمها viri قوية وتنمو م عليها ف ال Optochin😅
-الصورة الثانية من @Monzirelnino ✨
-ووبكدا خلصنا سلسلة التغريدات الخاصة بالمايكرو المختبر الي حقيقي تشوفوا فيه كل الأشكال والألوان وتقولوا سبحان الله كييفف!!!💛💛💛
-طبعًا دا شيء قليل جدًّا من كل الي بيصير جوا المختبر وباذن الله لقدام نتكلم عنه أكثر✨
-الي عنده إضافة يضيفها تحت التغريدة ليستفيد الجميع😍
-طبعًا دا شيء قليل جدًّا من كل الي بيصير جوا المختبر وباذن الله لقدام نتكلم عنه أكثر✨
-الي عنده إضافة يضيفها تحت التغريدة ليستفيد الجميع😍
Loading suggestions...